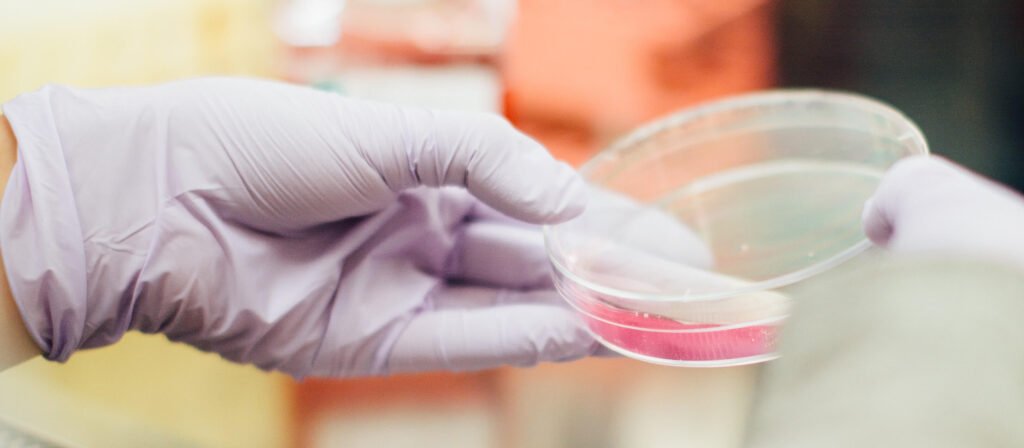

НАУКОВА ДІЯЛЬНІСТЬ
Фундаментальні дослідження
Інститут мікробіології і вірусології ім. Д.К. Заболотного НАН України – найбільший і провідний в Україні науковий заклад в галузі мікробіології, вірусології і мікробної біотехнології, що займається фундаментальними дослідженнями систематики, фізіології, біохімії, генетики і екології різних груп бактерій, мікроскопічних грибів і вірусів, а також розробкою наукових основ біотехнологічних препаратів і процесів на основі мікроорганізмів для сільського господарства промисловості, медицини, ветеринарії і охорони навколишнього середовища.
Прикладні дослідження
В рамках досліджень прикладних аспектів на базі Інституту було створено низку розробок для різних галузей господарства.
ПРОСИМО ДОЛУЧИТИСЯ ДО ОПИТУВАННЯ ПРОГРАМИ
Проєкт освітньо-наукової програми«Вірусологія»
на 2026–2027 навчальний рік
відгуки надсилали до 17 липня 2026 року
НОВИНИ І ОГОЛОШЕННЯ
- УкрІНТЕІ запрошує на науково-практичні семінари
Шановні науковці! Український інститут науково-технічної експертизи та інформації запрошує долучитися до науково-практичних семінарів, присвячених цифровій трансформації науково-технічної сфери та розвитку особистісних і професійних навичок. 23 червня 2026 р. о 11:00 відбудеться науково-практичний семінар на тему «Проблемні Читати далі - FEMS запрошує долучитися до Міжнародного дня мікроорганізмів 2026
17 вересня 2026 року відбудеться Міжнародний день мікроорганізмів (International Microorganism Day, IMD) – глобальна науково-просвітницька ініціатива, яку координує Федерація європейських мікробіологічних товариств (FEMS).Організаційна команда IMD повідомляє про початок приймання пропозицій щодо проведення заходів у межах Читати далі - Науковицю Інституту відзначено Подякою Київського міського голови
10 червня 2026 року в Колонній залі Київської міської державної адміністрації відбулися урочистості з нагоди професійного свята науковців – Дня науки в Україні.За вагомий внесок у розвиток наукової сфери відзнаками Київського міського голови було нагороджено Читати далі - Науковці Інституту взяли участь у Всеукраїнській конференції «Перспективи часникового бізнесу в Україні: переробка, вирощування та експорт 2026»
Червень – період активних польових робіт, коли науковий досвід і біотехнологічні розробки Інституту мікробіології і вірусології ім. Д.К. Заболотного НАН України є особливо актуальними і затребуваними для аграрного сектору. 5 червня 2026 року співробітниці Інституту Читати далі - Науковиця Інституту поділиться досвідом участі у програмі MSCA4Ukraine
12 червня 2026 року о 14:00 відбудеться третій семінар із серії онлайн-заходів Ради молодих вчених НАН України «Досвід участі молодих вчених в міжнародних грантових програмах». Доповідачка – Марічка ЗЛАТОГУРСЬКА, кандидат біологічних наук, наукова співробітниця відділу Читати далі - Доповідь науковиці Інституту на засіданні секції мікології та фітопатології Українського ботанічного товариства
28 травня 2026 року в актовому залі Інституту ботаніки ім. М. Г. Холодного НАН України відбулося чергове засідання секції мікології та фітопатології Українського ботанічного товариства. З доповіддю «Проблема грибостійкості історичних об’єктів в Україні» виступила керівниця Читати далі
АКРЕДИТОВАНІ ЛАБОРАТОРІЇ
Лабораторія з контролю якості біологічних препаратів
Лабораторія входить до переліку рекомендованих лабораторій, уповноважених Державною службою України з лікарських засобів

Випробувальна лабораторія грибостійкості і мікробіологічних досліджень технічних, медичних виробів і матеріалів
Компетентність лабораторії забезпечується відповідно до вимог ДСТУ ISO/IEC 17025:2006













